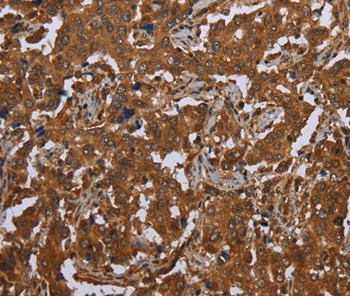
Anti-SCGB1D2 Antibody

Immunohistochemical staining of human cervix, uterine shows strong granular cytoplasmic positivity in glandular cells.
Anti-SCGB1D2 Antibody
HPA035318
ApplicationsImmunoHistoChemistry
Product group Antibodies
ReactivityHuman
TargetSCGB1D2
Overview
- SupplierAtlas Antibodies
- Product NameAnti-SCGB1D2 Antibody
- Delivery Days Customer4
- ApplicationsImmunoHistoChemistry
- CertificationResearch Use Only
- ClonalityPolyclonal
- ConjugateUnconjugated
- Gene ID10647
- Target nameSCGB1D2
- Target descriptionsecretoglobin family 1D member 2
- Target synonymsLIPB, LPHB, LPNB, secretoglobin family 1D member 2, lipophilin-B, prostatein-like lipophilin B
- HostRabbit
- IsotypeIgG
- Protein IDO95969
- Protein NameSecretoglobin family 1D member 2
- Scientific DescriptionRecombinant Protein Epitope Signature Tag (PrEST) antigen sequence
- ReactivityHuman
- Storage Instruction-20°C,2°C to 8°C
- UNSPSC41116161